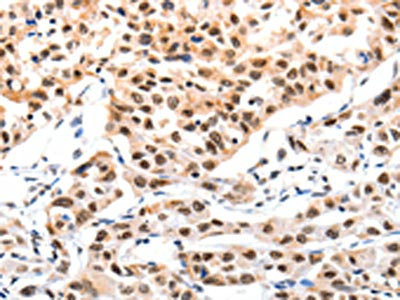

CBX8 Antibody
-
中文名稱:CBX8兔多克隆抗體
-
貨號:CSB-PA557525
-
規(guī)格:¥1100
-
圖片:
-
The image on the left is immunohistochemistry of paraffin-embedded Human lung cancer tissue using CSB-PA557525(CBX8 Antibody) at dilution 1/10, on the right is treated with fusion protein. (Original magnification: ×200)
-
Gel: 10%SDS-PAGE, Lysate: 40 μg, Lane 1-3: 231 cells, Hela cells, A549 cells, Primary antibody: CSB-PA557525(CBX8 Antibody) at dilution 1/200, Secondary antibody: Goat anti rabbit IgG at 1/8000 dilution, Exposure time: 1 minute
-
-
其他:
產(chǎn)品詳情
-
Uniprot No.:
-
基因名:CBX8
-
別名:Cbx8 antibody; CBX8_HUMAN antibody; Chromobox Homolog 8 (Drosophila Pc Class) antibody; Chromobox Homolog 8 (Pc Class Homolog; Drosophila) antibody; Chromobox Homolog 8 antibody; Chromobox protein homolog 8 antibody; hPc3 antibody; Pc Class 3 Homolog (Drosophila) antibody; Pc Class 3 Homolog antibody; Pc3 antibody; Polycomb 3 antibody; Polycomb 3 homolog antibody; RC1 antibody; Rectachrome 1 antibody
-
宿主:Rabbit
-
反應(yīng)種屬:Human,Mouse
-
免疫原:Fusion protein of Human CBX8
-
免疫原種屬:Homo sapiens (Human)
-
標(biāo)記方式:Non-conjugated
-
抗體亞型:IgG
-
純化方式:Antigen affinity purification
-
濃度:It differs from different batches. Please contact us to confirm it.
-
保存緩沖液:-20°C, pH7.4 PBS, 0.05% NaN3, 40% Glycerol
-
產(chǎn)品提供形式:Liquid
-
應(yīng)用范圍:ELISA,WB,IHC
-
推薦稀釋比:
Application Recommended Dilution ELISA 1:2000-1:5000 WB 1:500-1:2000 IHC 1:10-1:50 -
Protocols:
-
儲(chǔ)存條件:Upon receipt, store at -20°C or -80°C. Avoid repeated freeze.
-
貨期:Basically, we can dispatch the products out in 1-3 working days after receiving your orders. Delivery time maybe differs from different purchasing way or location, please kindly consult your local distributors for specific delivery time.
-
用途:For Research Use Only. Not for use in diagnostic or therapeutic procedures.
相關(guān)產(chǎn)品
靶點(diǎn)詳情
-
功能:Component of a Polycomb group (PcG) multiprotein PRC1-like complex, a complex class required to maintain the transcriptionally repressive state of many genes, including Hox genes, throughout development. PcG PRC1 complex acts via chromatin remodeling and modification of histones; it mediates monoubiquitination of histone H2A 'Lys-119', rendering chromatin heritably changed in its expressibility.
-
基因功能參考文獻(xiàn):
- CBX8 functions as an oncogene to upregulate EGR1 and miR-365-3p to stimulate the AKT/beta-catenin pathway in hepatocellular carcinoma.CBX8 expression is increased and associated with poor outcomes in hepatocellular carcinoma. PMID: 29066512
- CBX8 binds with the Snai1 promoter, represses Snai1 transcription and suppresses esophageal carcinoma metastasis. PMID: 28912889
- The data suggest that high expression of CBX8 plays a critical oncogenic role in aggressiveness of urothelial carcinoma cells of the bladder through promoting cancer cell proliferation by repressing the p53 pathway, and CBX8 could be used as a novel predictor for muscle invasive bladder cancer patients. PMID: 28837252
- CBX8 binds to H3K27me3 at bivalent promoters during germinal center formation, and recruits a novel PRC1-BCOR complex at BCL6 binding sites to specifically silence genes in the germinal center and promote lymphomagenesis PMID: 27505670
- CBX8 plates roles in epigenetic regulation in DNA damage response. PMID: 27555324
- IGF1 can promote the colon cancer cell line, HCT116 cell, proliferation via promoting Cbx8 expression PMID: 25398592
- The difference in the SUZ12 and CBX8 genes expression were significantly divergent between tumors and their marginal tissues. PMID: 26837964
- These data suggest that CBX8 modulates SIPS through the RB-E2F1 pathway in CML cells and provide important insight into its application in CML treatment. PMID: 26718407
- Low CBX8 expression was associated with distant metastasis in colorectal cancer. PMID: 25360999
- CBX8 might emerge as an oncogene for promoting the proliferation of tumor cells and raising the resistance of neoplasms to chemotherapy. PMID: 25197352
- The presence of CBX8-GFP in the same focus had a minor impact on BMI1 and RING1 recovery kinetics. PMID: 24460908
- Interaction with CBX8 precludes AF9-DOT1L binding. PMID: 23891621
- CBX8 cooperated with SIRT1 for suppressing p53 acetylation induced by Sirtinol and etoposide/TSA. Upon ectopic expression, CBX8 or SIRT1 repressed the expression of p21(WAF1) by inhibiting p53 binding to the promoter. PMID: 23474493
- CBX8 plays an essential role in MLL-AF9 transcriptional regulation and leukemogenesis. PMID: 22094252
- CBX8 is an essential component of one of the polycomb repressive complexes, which directly regulate the expression of numerous target genes, including the INK4A-ARF locus, involved in cell-fate decisions. PMID: 17332741
顯示更多
收起更多
-
亞細(xì)胞定位:Nucleus.
-
數(shù)據(jù)庫鏈接:
Most popular with customers
-
-
YWHAB Recombinant Monoclonal Antibody
Applications: ELISA, WB, IHC, IF, FC
Species Reactivity: Human, Mouse, Rat
-
Phospho-YAP1 (S127) Recombinant Monoclonal Antibody
Applications: ELISA, WB, IHC
Species Reactivity: Human
-
-
-
-
-